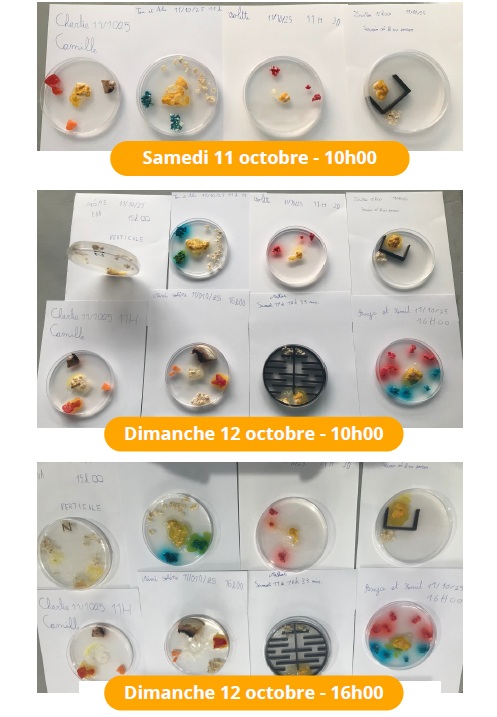

Les expériences et posters réalisés par les élèves de l’école Valène et du collège François-Villon ont été exposés dans l’Espace-Brassens le 11 et 12 octobre. Les enfants ont poursuivi les expériences avec les personnels éducatifs.
Les photos reçues sont publiées sur cette page.

Stand très suivi, celui de l’atelier Blob, où les enfants étaient conviés à observer, commenter les expériences en cours et proposer leurs idées d’expériences, avec l’aide bienveillante des membres de la Commission scolaires de l’ASTEC-PSL. Nommer les petits blobs, décrire les résultats, planifier de nouveaux essais, tout ce petit monde s’en est donné à cœur joie !












Sur le stand, des enfants saint-gillois regardent le film produit par la chercheuse CNRS Audrey Dussutour, grande spécialiste du Blob.
Dans des boîtes de Petri, les enfants ont disposé des morceaux de blob (qui sont eux-mêmes de blobs) selon différents dispositifs expérimentaux : les blobs doivent se rapprocher de la nourriture, éviter ou contourner des obstacles plus ou moins compliqués, changer de couleur en mangeant des flocons d’avoine imbibés de colorants, etc. Les clichés successifs montrent les progrès accomplis par les blobs pour résoudre ces problèmes. Le blob se révèle être une source d’émerveillement et d’amusement inépuisable !